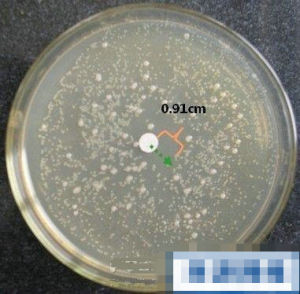
痰培養 痰培養

正常值
陰性,即無致病菌生長。
臨床意義
該項檢查試用於各種不明原因的呼吸道感染疾病。
痰液培養出致病菌後,進行菌種鑑定,可得出相應的病原菌。常見的致病菌有:
(1)革蘭陽性菌:肺炎鏈球菌、金黃色葡萄球菌、結核分枝桿菌、放線菌、奴卡菌、厭氧球菌、白喉棒狀桿菌等。
(2)革蘭陰性菌:卡他布蘭漢菌、腦膜炎奈瑟菌、流感嗜血桿菌、肺炎克雷伯菌、大腸桿菌、假單胞菌、軍團菌等。
(3)培養分離出一些真菌,有助於真菌性感染的診斷。 (4)做病毒分離:可分離到某些病毒,如分離到禽流感病毒H5N1,則可診斷為禽流感。
注意事項
(1)由於咳痰標本常受到口咽部定居細菌的污染,分離得到的細菌往往不能真正代表下呼吸道感染的病原菌,應密切結合臨床進行分析,必要時進行多次培養。
(2)痰液的細胞學篩選:將痰液直接塗片後光學顯微鏡檢查,每低倍視野鱗狀上皮細胞小於10個,白細胞大於25個,或鱗狀上皮細胞:白細胞< 1:2.5,可認為痰液來源於下呼吸道,即為合格痰標本。
(3)由於痰的非均質性,定量培養之前需先將標本液化和勻化。
(4)採樣前使用過抗菌藥物者,檢測到的感染菌濃度降低,可導致假陰性結果。
相關疾病
變形桿菌肺炎,大腸埃希桿菌肺炎,小腸結腸炎耶爾森菌肺炎,奈瑟卡他球菌肺炎,枸櫞酸桿菌肺炎,小兒嗜血流感桿菌肺炎,軍團病肺炎,金黃色葡萄球菌肺炎,洋蔥假單胞菌肺炎,社會獲得性肺炎等。
相關症狀
痰鳴音,濕咳,結核中毒,無活動性結核病灶,平臥呼吸困難,痰黏稠或膿性可有腥臭味,痰呈白色黏稠膠凍狀,隱球菌囊膜多糖堆積,隱球菌感染 ,濕囉音等。